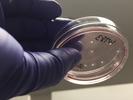

Jon Hamilton appears in the following:
Scientists Find Imperfections In 'Minibrains' That Raise Questions For Research
Wednesday, January 29, 2020
Brain organoids grown in the lab look a lot like developing human brains. But a new study finds some important differences that could affect how scientists use them.
Scientists Sent Mighty Mice To Space To Improve Treatments Back On Earth
Thursday, January 16, 2020
Forty mice spent more than a month in orbit to test two approaches to strengthening muscle and bone in microgravity conditions. The results could help people with muscle and bone diseases.
Scientists Reach Out To Minority Communities To Diversify Alzheimer's Studies
Tuesday, December 17, 2019
Black and Hispanic people often don't volunteer for studies of Alzheimer's disease, despite their risks for developing it. Researchers are working to make studies more inclusive, but it's not easy.
A Cancer Drug For Parkinson's? New Study Raises Hope, Draws Criticism
Monday, December 16, 2019
A leukemia drug seemed to help patients with Parkinson's disease. But critics say the results are equivocal and could raise false hopes.
Medical Students Say Their Opioid Experiences Will Shape How They Prescribe
Tuesday, November 26, 2019
One medical student was addicted to opioids. Another relied on them to control disabling pain. Both think their experiences will help them be better doctors when it comes to prescribing opioids.
The Loudness Of Vowels Helps The Brain Break Down Speech Into Syl-La-Bles
Wednesday, November 20, 2019
Syllables are the building blocks of spoken language. And now a study of brain activity hints at how we extract them from a stream of speech.
When It Comes To Vaping, Health Officials Insist There's A Lot At Stake
Tuesday, November 19, 2019
A former vaper has a warning for others. And, scientists work to understand how nicotine affects the teenage brain. (This segment initially aired on Oct. 10, 2019 on Morning Edition.)
Jimmy Carter Surgery: 'No Complications' In Bid To Relieve Pressure On His Brain
Tuesday, November 12, 2019
Former President Jimmy Carter, 95, was admitted to Emory University Hospital on Monday evening for the procedure. He was accompanied by his wife, Rosalynn.
New Study Challenges The Assumption That Math Is Harder For Girls
Friday, November 08, 2019
Research shows that when boys and girls as old as 10 do math, their patterns of brain activity are indistinguishable. The finding is the latest challenge to the idea that math is harder for girls.
Math Looks The Same In The Brains Of Boys And Girls, Study Finds
Friday, November 08, 2019
Brain scans of 104 boys and girls doing basic math tasks found no gender differences. The finding adds to the evidence that boys and girls start out with equal ability in math.
How Deep Sleep May Help The Brain Clear Alzheimer's Toxins
Thursday, October 31, 2019
A study of 11 sleeping brains sheds some light on the mysterious link between sleep problems and Alzheimer's disease. The flow of cerebrospinal fluid through the brain appears to be the key.
U.S. Travel Ban Disrupts The World's Largest Brain Science Meeting
Thursday, October 24, 2019
Scientists from nations including Iran, Mexico, and India were refused visas to attend this year's Society for Neuroscience meeting in Chicago. Some researchers got stand-ins to present their work.
Keeping Your Blood Sugar In Check Could Lower Your Alzheimer's Risk
Monday, October 21, 2019
Diabetes can double a person's chances of developing Alzheimer's. Now researchers are beginning to understand the role of brain metabolism in the development of the disease.
Low Blood Sugar Levels May Keep Alzheimer's At Bay
Monday, October 21, 2019
People with diabetes are more likely to develop Alzheimer's disease. Researchers say they are beginning to understand why, and the answer has to do with the way the brain uses sugar.
Gifted Students With Autism Find An Intellectual Oasis In Iowa
Wednesday, October 16, 2019
A center at the University of Iowa is making sure that its programs for gifted teens include those with autism spectrum disorders.
How Vaping Nicotine Can Affect A Teenage Brain
Thursday, October 10, 2019
Research on young mice and rats shows how nicotine hijacks brain systems involved in learning, memory, impulse control and addiction.
Too Much Training Can Tax Athletes' Brains
Thursday, September 26, 2019
Research finds that triathletes who train too hard can impair a brain area involved in achieving goals such as winning a race. Fatigued athletes choose immediate gratification over long-term rewards.
Deadly Brain Cancers Act Like 'Vampires' By Hijacking Normal Cells To Grow
Wednesday, September 18, 2019
Researchers say certain brain cancers tap electrical signals from healthy cells to fuel their growth. The finding could lead to treatments for deadly tumors like the one that killed Sen. John McCain.
Esketamine Nasal Spray Eases Depression Symptoms In Suicidal Patients
Monday, September 09, 2019
Spravato, a nasal spray of the anesthetic ketamine, has been shown to help people with major depression. Now studies show it can relieve depressive symptoms in people actively considering suicide.
After Months In A Dish, Lab-Grown Minibrains Start Making 'Brain Waves'
Thursday, August 29, 2019
Researchers say clusters of human brain cells grown in the lab can spontaneously generate electrical patterns similar to the brain waves of a 6-month-old fetus.